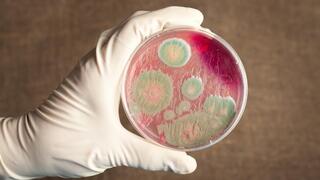
מחלת גחלת כתוצאה מחיידק אנתרקס מחלת גחלת כתוצאה מחיידק אנתרקס

גבר בן 53 מת לאחר שנדבק בחיידק המסוכן אנתרקס בצפון מזרח תאילנד ליד הגבול עם לאוס. עוד מקרה שני של חולה גחלת אומת באותו המחוז ושלושה מקרים בבדיקה. 638 אנשים הנחשבים ל"קבוצות סיכון" מקבלים אנטיביוטיקה כצעד מונע. הרשויות בתאילנד מזהירות מפני אכילת בשר נא
Source link